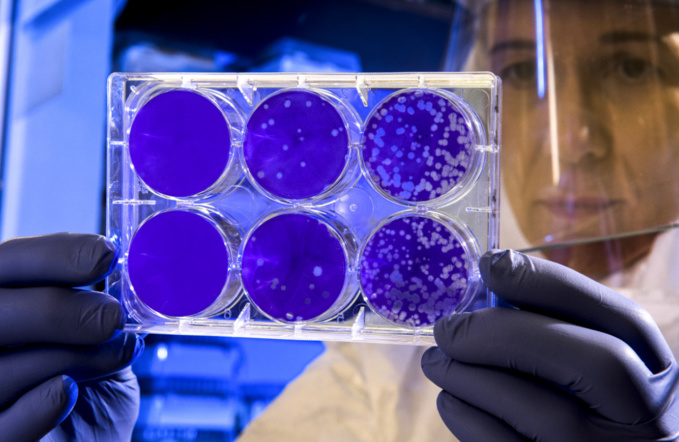
pxhere pxhere

According to the People's Republic of China's State Health and Hygiene Committee, an 87-year-old man from Beijing passed away on Nov. 20. With this, there have now been 5,227 coronavirus fatalities on Chinese territory. The prior fatalities were reported in Shanghai, where the disease experienced a substantial springtime rise, according to the Associated Press (AP).
China also revealed that 24,215 new cases had been found in the previous day, the great majority of which lacked symptoms.
Since the virus was originally discovered in the city of Wuhan, with a population of 1.4 billion, in late 2019, China has only formally registered 286.197 cases, the AP observed. According to the government, since the virus was discovered there in 2020, there have been documented 98.3 million illnesses and 1 million deaths in the U.S., which has a population of 331.9 million.
To stop a second COVID-19 epidemic, tough new regulations are currently in place in Beijing and throughout China.
source: apnews.com
China also revealed that 24,215 new cases had been found in the previous day, the great majority of which lacked symptoms.
Since the virus was originally discovered in the city of Wuhan, with a population of 1.4 billion, in late 2019, China has only formally registered 286.197 cases, the AP observed. According to the government, since the virus was discovered there in 2020, there have been documented 98.3 million illnesses and 1 million deaths in the U.S., which has a population of 331.9 million.
To stop a second COVID-19 epidemic, tough new regulations are currently in place in Beijing and throughout China.
source: apnews.com